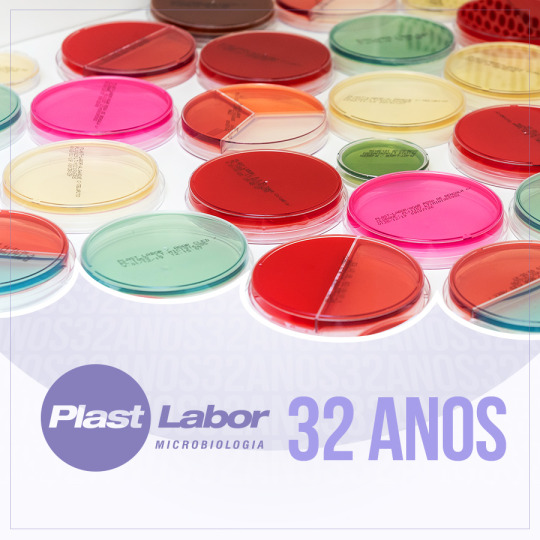
Plastlabor 32 anos

Em novembro a Plast Labor comemorou 32 anos de fundação e tem números grandiosos para comprovar os motivos da empresa ser uma das maiores do país, no segmento de produtos prontos para uso em microbiologia. No entanto, não seria possível retratar em números toda a conjuntura política, econômica e social que a empresa passou de 1987 até os dias atuais. Só como um breve registro foram cinco moedas diferentes, oito Presidentes da República e a consolidação da Internet como um meio de comunicação.
O começo
A empresa nasceu com a venda de materiais de laboratório, mas com a percepção de que o mercado ainda tinha uma abertura para novos produtos na área de microbiologia, lançou as ponteiras de plástico para transferência de reagentes.
Ainda não havia demanda o suficiente para absorver a produção. Então, para criar a cultura, Wagner Garcia, passou a doar as ponteiras de plástico aos laboratórios. Em paralelo o mercado começou utilizar materiais descartáveis, outras empresas passaram a investir no segmento e paulatinamente o produto passou ter um aumento em seu volume de vendas.
Desenvolvimento da ideia
Ainda na década de 1990, com o conhecimento pela participação em congressos da área, o crescimento dos cuidados com as análises microbiológicas e os laboratórios pressionados por uma cultura internacional em utilizar materiais descartáveis, Wagner observou uma oportunidade e decidiu diversificar a produção.
Com isso foi feita uma nova remodelação da fábrica para a produção de placas com meios de cultura prontos para uso. O primeiro cliente foi o laboratório Sergio Franco, que apostou na qualidade do produto que a empresa estava lançando. Porém, para ganhar mercado, a Plast Labor utilizou uma prática incomum para a época: deixava algumas placas para teste e oferecia a garantia de troca no caso de desvios. Prática que ainda é adotada pela Plast Labor.
Mesmo com o crescimento acelerado, a produção era baseada somente nos meios de cultura. Em 2011, após a decisão da fornecedora das placas de petri, um dos principais insumos, em descontinuar a produção, a Plast Labor decidiu ampliar novamente seu escopo de produtos e incorporou a fabricação das placas de petri, como um produto da empresa, verticalizando assim a sua produção.
A modernização
No começo tudo era feito de forma manual, o que causava muitos problemas e custos elevados. Foram quase 10 anos para a produção se tornar autossustentável. Dentro da empresa, a curva de aprendizado precisou ser rápida e foram feitos investimentos em equipamentos e capacitação, para não perder mercado para empresas internacionais que começaram a observar o Brasil como um mercado promissor.
Em paralelo, foram feitos investimentos constantes em tecnologia, o que chamou a atenção de empresas internacionais. Atualmente, a Plast Labor é representante no país de algumas das principais marcas no setor de produtos para microbiologia.
Os investimentos em melhoria dos processos e qualidade transformaram a empresa em um ambiente convidativo para profissionais do mercado. Andrea Costa, atualmente é Analista de Garantia de Qualidade, conta que sua experiência como cliente da Plast Labor foi fundamental quando resolveu se candidatar à uma vaga de trabalho na empresa.
“Eu como cliente via a atenção da Plast Labor com as suas entregas e hoje, no outro lado, consigo entender a importância que a empresa tem com a manutenção na qualidade do produto que é entregue ao cliente, conta Andrea.
Próximos passos
Atualmente, a fabricação está dividida em três unidades da empresa. Uma nova fábrica está em construção e terá como principal característica uma maior automação e a capacidade de absorver tecnologias emergentes que possam aperfeiçoar o processo produtivo sem grandes impactos para a produção diária.

